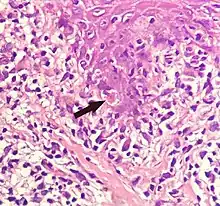

Keratinocyte
Keratinocytes are the primary type of cell found in the epidermis, the outermost layer of the skin. In humans, they constitute 90% of epidermal skin cells. [1] Basal cells in the basal layer (stratum basale) of the skin are sometimes referred to as basal keratinocytes.[2] Keratinocytes form a barrier against environmental damage by heat, UV radiation, water loss, pathogenic bacteria, fungi, parasites, and viruses. A number of structural proteins, enzymes, lipids, and antimicrobial peptides contribute to maintain the important barrier function of the skin. Keratinocytes differentiate from epidermal stem cells in the lower part of the epidermis and migrate towards the surface, finally becoming corneocytes and eventually be shed off,[3][4][5][6] which happens every 40 to 56 days in humans.[7]


Function
The primary function of keratinocytes is the formation of a barrier against environmental damage by heat, UV radiation, water loss, pathogenic bacteria, fungi, parasites, and viruses.
Pathogens invading the upper layers of the epidermis can cause keratinocytes to produce proinflammatory mediators, particularly chemokines such as CXCL10 and CCL2 (MCP-1) which attract monocytes, natural killer cells, T-lymphocytes, and dendritic cells to the site of pathogen invasion.[8]
Structure
A number of structural proteins (filaggrin, keratin), enzymes (proteases), lipids, and antimicrobial peptides (defensins) contribute to maintain the important barrier function of the skin. Keratinization is part of the physical barrier formation (cornification), in which the keratinocytes produce more and more keratin and undergo terminal differentiation. The fully cornified keratinocytes that form the outermost layer are constantly shed off and replaced by new cells.[3]
Cell differentiation
Epidermal stem cells reside in the lower part of the epidermis (stratum basale) and are attached to the basement membrane through hemidesmosomes. Epidermal stem cells divide in a random manner yielding either more stem cells or transit amplifying cells.[4] Some of the transit amplifying cells continue to proliferate then commit to differentiate and migrate towards the surface of the epidermis. Those stem cells and their differentiated progeny are organized into columns named epidermal proliferation units.[5]
During this differentiation process, keratinocytes permanently withdraw from the cell cycle, initiate expression of epidermal differentiation markers, and move suprabasally as they become part of the stratum spinosum, stratum granulosum, and eventually corneocytes in the stratum corneum.
Corneocytes are keratinocytes that have completed their differentiation program and have lost their nucleus and cytoplasmic organelles.[6] Corneocytes will eventually be shed off through desquamation as new ones come in.
At each stage of differentiation, keratinocytes express specific keratins, such as keratin 1, keratin 5, keratin 10, and keratin 14, but also other markers such as involucrin, loricrin, transglutaminase, filaggrin, and caspase 14.
In humans, it is estimated that keratinocytes turn over from stem cells to desquamation every 40–56 days,[7] whereas in mice the estimated turnover time is 8–10 days.[9]
Factors promoting keratinocyte differentiation are:
- A calcium gradient, with the lowest concentration in the stratum basale and increasing concentrations until the outer stratum granulosum, where it reaches its maximum. Calcium concentration in the stratum corneum is very high in part because those relatively dry cells are not able to dissolve the ions.[10] Those elevations of extracellular calcium concentrations induces an increase in intracellular free calcium concentrations in keratinocytes.[11] Part of that intracellular calcium increase comes from calcium released from intracellular stores[12] and another part comes from transmembrane calcium influx,[13] through both calcium-sensitive chloride channels[14] and voltage-independent cation channels permeable to calcium.[15] Moreover, it has been suggested that an extracellular calcium-sensing receptor (CaSR) also contributes to the rise in intracellular calcium concentration.[16]
- Vitamin D3 (cholecalciferol) regulates keratinocyte proliferation and differentiation mostly by modulating calcium concentrations and regulating the expression of genes involved in keratinocyte differentiation.[17][18] Keratinocytes are the only cells in the body with the entire vitamin D metabolic pathway from vitamin D production to catabolism and vitamin D receptor expression.[19]
- Cathepsin E.[20]
- TALE homeodomain transcription factors.[21]
- Hydrocortisone.[22]
Since keratinocyte differentiation inhibits keratinocyte proliferation, factors that promote keratinocyte proliferation should be considered as preventing differentiation. These factors include:
- The transcription factor p63, which prevents epidermal stem cells from differentiating into keratinocytes.[23] Mutations in the p63 DNA-binding domain are associated with ectrodactyly, ectodermal dysplasia, and cleft lip/palate (EEC) syndrome. The transcriptome of p63 mutant keratinocytes deviated from the normal epidermal cell identity. [24]
- Vitamin A and its analogues.[25]
- Epidermal growth factor.[26]
- Transforming growth factor alpha.[27]
- Cholera toxin.[22]
Interaction with other cells
Within the epidermis keratinocytes are associated with other cell types such as melanocytes and Langerhans cells. Keratinocytes form tight junctions with the nerves of the skin and hold the Langerhans cells and intra-dermal lymphocytes in position within the epidermis. Keratinocytes also modulate the immune system: apart from the above-mentioned antimicrobial peptides and chemokines they are also potent producers of anti-inflammatory mediators such as IL-10 and TGF-β. When activated, they can stimulate cutaneous inflammation and Langerhans cell activation via TNFα and IL-1β secretion.
Keratinocytes contribute to protecting the body from ultraviolet radiation (UVR) by taking up melanosomes, vesicles containing the endogenous photoprotectant melanin, from epidermal melanocytes. Each melanocyte in the epidermis has several dendrites that stretch out to connect it with many keratinocytes. The melanin is then stored within keratinocytes and melanocytes in the perinuclear area as supranuclear “caps”, where it protects the DNA from UVR-induced damage.[28]
Role in wound healing
Wounds to the skin will be repaired in part by the migration of keratinocytes to fill in the gap created by the wound. The first set of keratinocytes to participate in that repair come from the bulge region of the hair follicle and will only survive transiently. Within the healed epidermis they will be replaced by keratinocytes originating from the epidermis.[29][30]
At the opposite, epidermal keratinocytes, can contribute to de novo hair follicle formation during the healing of large wounds.[31]
Functional keratinocytes are needed for tympanic perforation healing.[32]
Sunburn cells
A sunburn cell is a keratinocyte with a pyknotic nucleus and eosinophilic cytoplasm that appears after exposure to UVC or UVB radiation or UVA in the presence of psoralens. It shows premature and abnormal keratinization, and has been described as an example of apoptosis.[33][34]
Aging
With age, tissue homeostasis declines partly because stem/progenitor cells fail to self-renew or differentiate. DNA damage caused by exposure of stem/progenitor cells to reactive oxygen species (ROS) may play a key role in epidermal stem cell aging. Mitochondrial superoxide dismutase (SOD2) ordinarily protects against ROS. Loss of SOD2 in mouse epidermal cells was observed to cause cellular senescence that irreversibly arrested proliferation in a fraction of keratinocytes.[35] In older mice, SOD2 deficiency delayed wound closure and reduced epidermal thickness.[35]
Civatte body
A Civatte body (named after the French dermatologist Achille Civatte, 1877–1956)[36] is a damaged basal keratinocyte that has undergone apoptosis, and consist largely of keratin intermediate filaments, and are almost invariably covered with immunoglobulins, mainly IgM.[37] Civatte bodies are characteristically found in skin lesions of various dermatoses, particularly lichen planus and discoid lupus erythematosus.[37] They may also be found in graft-versus-host disease, adverse drug reactions, inflammatory keratosis (such as lichenoid actinic keratosis and lichen planus-like keratosis), erythema multiforme, bullous pemphigoid, eczema, lichen planopilaris, febrile neutrophilic dermatosis, toxic epidermal necrolysis, herpes simplex and varicella zoster lesions, dermatitis herpetiformis, porphyria cutanea tarda, sarcoidosis, subcorneal pustular dermatosis, transient acantholytic dermatosis and epidermolytic hyperkeratosis.[37]
See also
References
- McGrath JA; Eady RAJ; Pope FM. (2004). "Anatomy and Organization of Human Skin". In Burns T; Breathnach S; Cox N; Griffiths C. (eds.). Rook's Textbook of Dermatology (7th ed.). Blackwell Publishing. p. 4190. doi:10.1002/9780470750520.ch3. ISBN 978-0-632-06429-8. Archived from the original on 2020-05-20. Retrieved 2010-06-01.
- James W, Berger T, Elston D (December 2005). Andrews' Diseases of the Skin: Clinical Dermatology (10th ed.). Saunders. pp. 5–6. ISBN 978-0-7216-2921-6. Archived from the original on 2010-10-11. Retrieved 2010-06-01.
- Gilbert, Scott F. (2000). "The Epidermis and the Origin of Cutaneous Structures.". Developmental Biology. Sinauer Associates. ISBN 978-0878932436.
Throughout life, the dead keratinized cells of the cornified layer are shed (humans lose about 1.5 grams of these cells each day*) and are replaced by new cells, the source of which is the mitotic cells of the Malpighian layer. Pigment cells (melanocytes) from the neural crest also reside in the Malpighian layer, where they transfer their pigment sacs (melanosomes) to the developing keratinocytes.
- Houben E, De Paepe K, Rogiers V (2007). "A keratinocyte's course of life". Skin Pharmacology and Physiology. 20 (3): 122–32. doi:10.1159/000098163. PMID 17191035. S2CID 25671082.
- Ghazizadeh S, Taichman LB (March 2001). "Multiple classes of stem cells in cutaneous epithelium: a lineage analysis of adult mouse skin". The EMBO Journal. 20 (6): 1215–22. doi:10.1093/emboj/20.6.1215. PMC 145528. PMID 11250888.
- Koster MI (July 2009). "Making an epidermis". Annals of the New York Academy of Sciences. 1170 (1): 7–10. Bibcode:2009NYASA1170....7K. doi:10.1111/j.1749-6632.2009.04363.x. PMC 2861991. PMID 19686098.
- Halprin KM (January 1972). "Epidermal "turnover time"--a re-examination". The British Journal of Dermatology. 86 (1): 14–9. doi:10.1111/j.1365-2133.1972.tb01886.x. PMID 4551262. S2CID 30165907.
- Murphy, Kenneth (Kenneth M.) (2017). Janeway's immunobiology. Weaver, Casey (Ninth ed.). New York, NY, USA. p. 112. ISBN 9780815345053. OCLC 933586700.
- Potten CS, Saffhill R, Maibach HI (September 1987). "Measurement of the transit time for cells through the epidermis and stratum corneum of the mouse and guinea-pig". Cell and Tissue Kinetics. 20 (5): 461–72. doi:10.1111/j.1365-2184.1987.tb01355.x. PMID 3450396. S2CID 22475141.
- Proksch E, Brandner JM, Jensen JM (December 2008). "The skin: an indispensable barrier". Experimental Dermatology. 17 (12): 1063–72. doi:10.1111/j.1600-0625.2008.00786.x. PMID 19043850. S2CID 31353914.
- Hennings H, Kruszewski FH, Yuspa SH, Tucker RW (April 1989). "Intracellular calcium alterations in response to increased external calcium in normal and neoplastic keratinocytes". Carcinogenesis. 10 (4): 777–80. doi:10.1093/carcin/10.4.777. PMID 2702726.
- Pillai S, Bikle DD (January 1991). "Role of intracellular-free calcium in the cornified envelope formation of keratinocytes: differences in the mode of action of extracellular calcium and 1,25 dihydroxyvitamin D3". Journal of Cellular Physiology. 146 (1): 94–100. doi:10.1002/jcp.1041460113. PMID 1990023. S2CID 21264605.
- Reiss, M; Lipsey, LR; Zhou, ZL (1991). "Extracellular calcium-dependent regulation of transmembrane calcium fluxes in murine keratinocytes". Journal of Cellular Physiology. 147 (2): 281–91. doi:10.1002/jcp.1041470213. PMID 1645742. S2CID 25858560.
- Mauro, TM; Pappone, PA; Isseroff, RR (1990). "Extracellular calcium affects the membrane currents of cultured human keratinocytes". Journal of Cellular Physiology. 143 (1): 13–20. doi:10.1002/jcp.1041430103. PMID 1690740. S2CID 8072916.
- Mauro, TM; Isseroff, RR; Lasarow, R; Pappone, PA (1993). "Ion channels are linked to differentiation in keratinocytes". The Journal of Membrane Biology. 132 (3): 201–9. doi:10.1007/BF00235738. PMID 7684087. S2CID 13063458.
- Tu, CL; Oda, Y; Bikle, DD (1999). "Effects of a calcium receptor activator on the cellular response to calcium in human keratinocytes". The Journal of Investigative Dermatology. 113 (3): 340–5. doi:10.1046/j.1523-1747.1999.00698.x. PMID 10469331.
- Hennings, Henry; Michael, Delores; Cheng, Christina; Steinert, Peter; Holbrook, Karen; Yuspa, Stuart H. (1980). "Calcium regulation of growth and differentiation of mouse epidermal cells in culture". Cell. 19 (1): 245–54. doi:10.1016/0092-8674(80)90406-7. PMID 6153576. S2CID 23896865.
- Su, MJ; Bikle, DD; Mancianti, ML; Pillai, S (1994). "1,25-Dihydroxyvitamin D3 potentiates the keratinocyte response to calcium". The Journal of Biological Chemistry. 269 (20): 14723–9. doi:10.1016/S0021-9258(17)36685-1. PMID 7910167.
- Fu, G. K.; Lin, D; Zhang, MY; Bikle, DD; Shackleton, CH; Miller, WL; Portale, AA (1997). "Cloning of Human 25-Hydroxyvitamin D-1 -Hydroxylase and Mutations Causing Vitamin D-Dependent Rickets Type 1". Molecular Endocrinology. 11 (13): 1961–70. CiteSeerX 10.1.1.320.3485. doi:10.1210/me.11.13.1961. PMID 9415400.
- Kawakubo, Tomoyo; Yasukochi, Atsushi; Okamoto, Kuniaki; Okamoto, Yoshiko; Nakamura, Seiji; Yamamoto, Kenji (2011). "The role of cathepsin E in terminal differentiation of keratinocytes". Biological Chemistry. 392 (6): 571–85. doi:10.1515/BC.2011.060. hdl:2324/25561. PMID 21521076. S2CID 21148292.
- Jackson, B.; Brown, S. J.; Avilion, A. A.; O'Shaughnessy, R. F. L.; Sully, K.; Akinduro, O.; Murphy, M.; Cleary, M. L.; Byrne, C. (2011). "TALE homeodomain proteins regulate site-specific terminal differentiation, LCE genes and epidermal barrier". Journal of Cell Science. 124 (10): 1681–1690. doi:10.1242/jcs.077552. PMC 3183491. PMID 21511732.
- Rheinwald, JG; Green, H (1975). "Serial cultivation of strains of human epidermal keratinocytes: The formation of keratinizing colonies from single cells". Cell. 6 (3): 331–43. doi:10.1016/S0092-8674(75)80001-8. PMID 1052771. S2CID 53294766.
- Truong, AB; Kretz, M; Ridky, TW; Kimmel, R; Khavari, PA (2006). "P63 regulates proliferation and differentiation of developmentally mature keratinocytes". Genes & Development. 20 (22): 3185–97. doi:10.1101/gad.1463206. PMC 1635152. PMID 17114587.
- Qu J, Tanis SE, Smits JP, Kouwenhoven EN, Oti M, van den Bogaard EH, Logie C, Stunnenberg HG, van Bokhoven H, Mulder KW, Zhou H (December 2018). "Mutant p63 affects epidermal cell identity through rewiring the enhancer landscape". Cell Reports. 25 (12): 3490–503. doi:10.1016/j.celrep.2018.11.039. PMID 30566872.
- Fuchs, E; Green, H (1981). "Regulation of terminal differentiation of cultured human keratinocytes by vitamin A". Cell. 25 (3): 617–25. doi:10.1016/0092-8674(81)90169-0. PMID 6169442. S2CID 23796587.
- Rheinwald, JG; Green, H (1977). "Epidermal growth factor and the multiplication of cultured human epidermal keratinocytes". Nature. 265 (5593): 421–4. Bibcode:1977Natur.265..421R. doi:10.1038/265421a0. PMID 299924. S2CID 27427541.
- Barrandon, Y; Green, H (1987). "Cell migration is essential for sustained growth of keratinocyte colonies: The roles of transforming growth factor-alpha and epidermal growth factor". Cell. 50 (7): 1131–7. doi:10.1016/0092-8674(87)90179-6. PMID 3497724. S2CID 21054962.
- Brenner M; Hearing VJ. (May–June 2008). "The Protective Role of Melanin Against UV Damage in Human Skin". Photochemistry and Photobiology. 84 (3): 539–549. doi:10.1111/j.1751-1097.2007.00226.x. PMC 2671032. PMID 18435612.
- Ito, M; Liu, Y; Yang, Z; Nguyen, J; Liang, F; Morris, RJ; Cotsarelis, G (2005). "Stem cells in the hair follicle bulge contribute to wound repair but not to homeostasis of the epidermis". Nature Medicine. 11 (12): 1351–4. doi:10.1038/nm1328. PMID 16288281. S2CID 52869761.
- Claudinot, S; Nicolas, M; Oshima, H; Rochat, A; Barrandon, Y (2005). "Long-term renewal of hair follicles from clonogenic multipotent stem cells". Proceedings of the National Academy of Sciences of the United States of America. 102 (41): 14677–82. Bibcode:2005PNAS..10214677C. doi:10.1073/pnas.0507250102. PMC 1253596. PMID 16203973.
- Ito, M; Yang, Z; Andl, T; Cui, C; Kim, N; Millar, SE; Cotsarelis, G (2007). "Wnt-dependent de novo hair follicle regeneration in adult mouse skin after wounding". Nature. 447 (7142): 316–20. Bibcode:2007Natur.447..316I. doi:10.1038/nature05766. PMID 17507982. S2CID 887738.
- Y Shen, Y Guo, C Du, M Wilczynska, S Hellström, T Ny, Mice Deficient in Urokinase-Type Plasminogen Activator Have Delayed Healing of Tympanic Membrane Perforations, PLOS ONE, 2012
- Young AR (June 1987). "The sunburn cell". Photodermatology. 4 (3): 127–134. PMID 3317295.
- Sheehan JM, Young AR (June 2002). "The sunburn cell revisited: an update on mechanistic aspects". Photochemical and Photobiological Sciences. 1 (6): 365–377. doi:10.1039/b108291d. PMID 12856704.
- Velarde MC, Demaria M, Melov S, Campisi J (August 2015). "Pleiotropic age-dependent effects of mitochondrial dysfunction on epidermal stem cells". Proc. Natl. Acad. Sci. U.S.A. 112 (33): 10407–12. Bibcode:2015PNAS..11210407V. doi:10.1073/pnas.1505675112. PMC 4547253. PMID 26240345.
- Crissey, John Thorne; Parish, Lawrence C.; Holubar, Karl (2002). Historical Atlas of Dermatology and Dermatologists. Boca Raton, FL: CRC Press. p. 147. ISBN 1-84214-100-7.
- Seema, Chhabra; Pranay, Tanwar; Kumar, AroraSandeep (2013). "Civatte bodies: A diagnostic clue". Indian Journal of Dermatology. 58 (4): 327. doi:10.4103/0019-5154.113974. ISSN 0019-5154. PMC 3726905. PMID 23919028.
External links
| Wikimedia Commons has media related to Keratinocytes. |